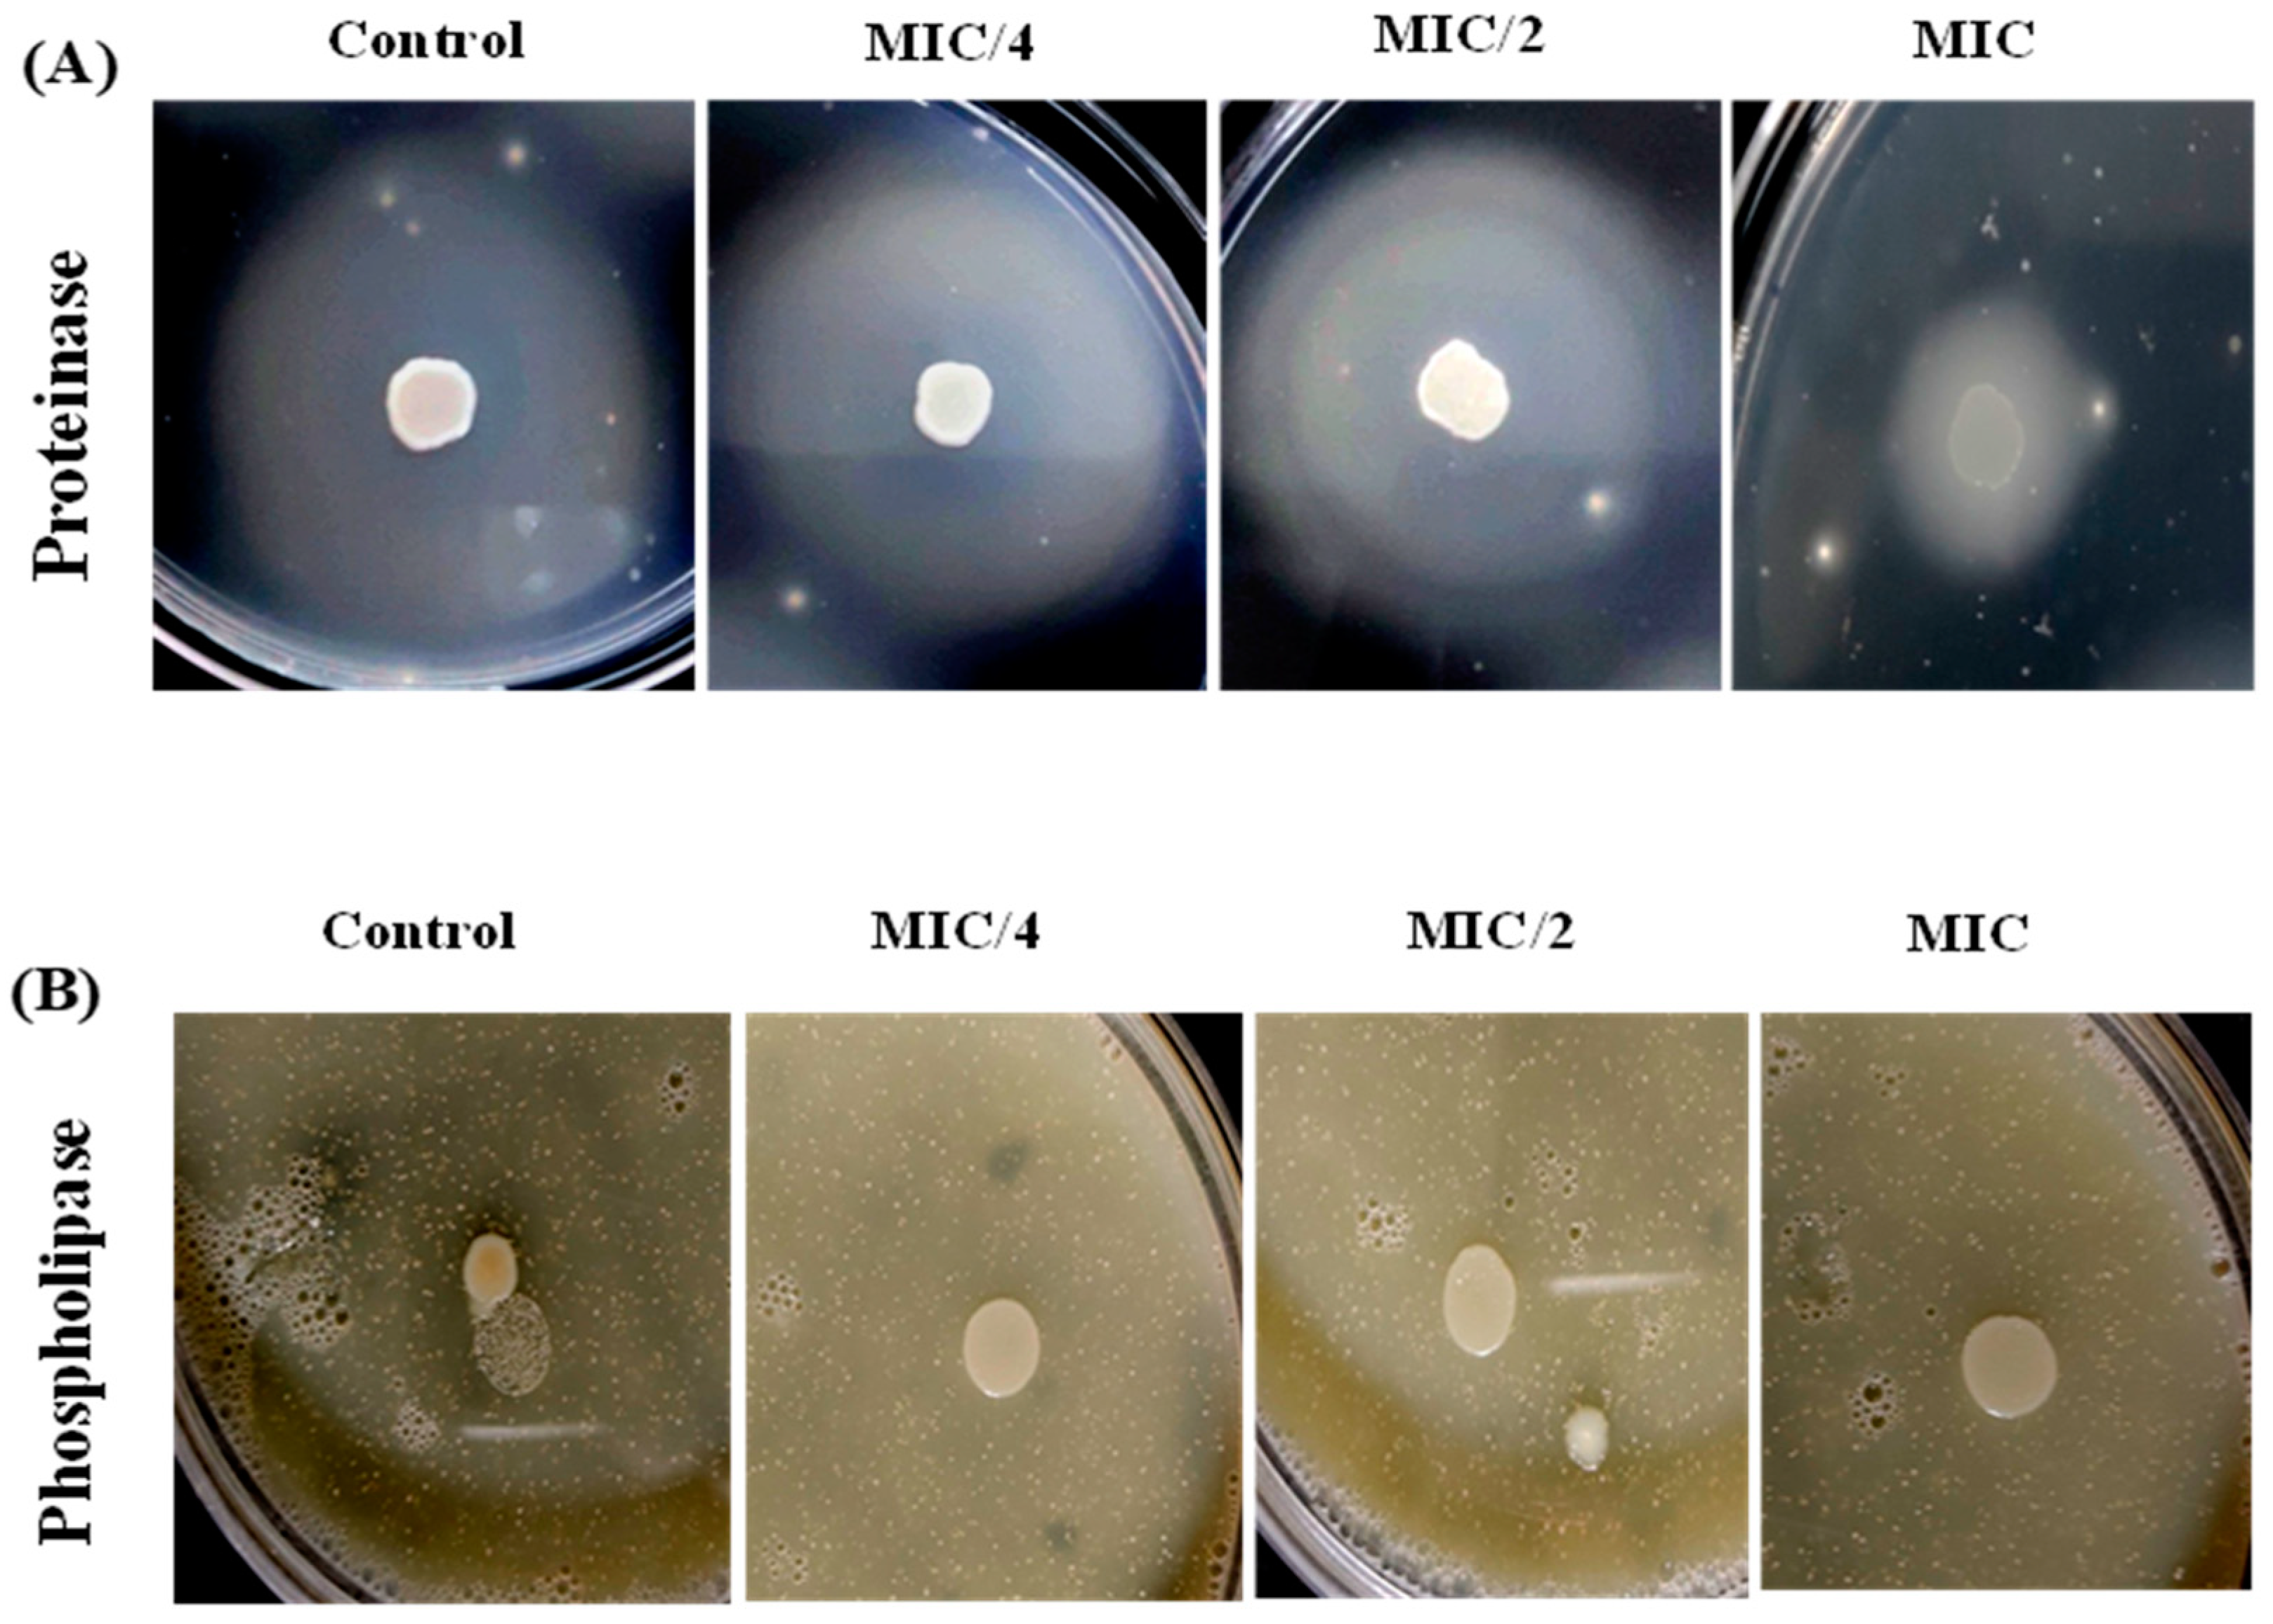
Msf 21 00050 g001

Signature Garlic Phytochemical as a Potential Anti-Candidal Candidate Targeting Virulence Factors in Candida albicans †
Abstract
:1. Introduction
2. Materials and Methods
2.1. Growth Parameters, Strain, Media and Chemicals Used
2.2. Determination of Antifungal Susceptibility
2.3. Determination of AMS Impact on Virulence
2.3.1. Proteinase and Phospholipase Assay
2.3.2. Buccal Epithelial Cells Adhesion Assay
2.3.3. Biofilm Formation Assay
2.3.4. Yeast to Hypha Virulence Trait
2.4. Statistical Analysis
3. Results
3.1. Antifungal Activity Determination
3.2. Effect of AMS against Virulence Traits of C. albicans
3.2.1. Effect on Proteinase and Phospholipase Secretion
3.2.2. Effect of AMS on Adherence to Host Epithelial Tissue
3.2.3. Effect of AMS on Biofilm Formation
3.2.4. Effect of AMS on Morphological Switching
4. Discussion
5. Conclusions
Author Contributions
Funding
Institutional Review Board Statement
Informed Consent Statement
Data Availability Statement
Acknowledgments
Conflicts of Interest
References
- Lopes, J.P.; Lionakis, M.S. Pathogenesis and virulence Candida albicans. Virulence 2022, 13, 89–121. [Google Scholar] [CrossRef] [PubMed]
- Hasan, Z.; Islam, A.; Khan, L.A. Spectroscopic investigations on fungal aspartic protease as target of gallic acid. Int. J. Biol. Macromol. 2023, 228, 333–345. [Google Scholar] [CrossRef] [PubMed]
- Hughes, B.G.; Lawson, L.D. Antimicrobial effects of Allium sativum L. (garlic), Allium ampeloprasum L. (elephant garlic), and Allium cepa L. (onion), garlic compounds and commercial garlic supplement products. Phytother. Res. 1991, 5, 154–158. [Google Scholar] [CrossRef]
- Pereira, R.; Mendes, J.D.F.S.; dos Santos Fontenelle, R.O.; Rodrigues, T.H.S.; dos Santos, H.S.; Marinho, E.S.; Marinho, M.; de Morais, S.M. Antifungal activity, antibiofilm, synergism and molecular docking of Allium sativum essential oil against clinical isolates of C. albicans. Res. Soc. Dev. 2021, 10, e313101220457. [Google Scholar] [CrossRef]
- Pundir, R.K.; Jain, P.; Sharma, C. Antimicrobial activity of ethanolic extracts of Syzygium aromaticum and Allium sativum against food associated bacteria and fungi. Ethnobot. Leafl. 2010, 2010, 11. [Google Scholar]
- Sato, S.; Sekine, Y.; Kakumu, Y.; Hiramoto, T. Measurement of diallyl disulfide and allyl methyl sulfide emanating from human skin surface and influence of ingestion of grilled garlic. Sci. Rep. 2020, 10, 465. [Google Scholar] [CrossRef] [PubMed]
- Leontiev, R.; Hohaus, N.; Jacob, C.; Gruhlke, M.C.; Slusarenko, A.J. A comparison of the antibacterial and antifungal activities of thiosulfinate analogues of allicin. Sci. Rep. 2018, 8, 6763. [Google Scholar] [CrossRef] [PubMed]
- CLSI M27; Reference Method for Broth Dilution Antifungal Susceptibility Testing of Yeasts, Approved Standard. Clinical and Laboratory Standards Institute: Wayne, PA, USA, 2002.
- Costa, P.D.S.; Cruz, E.; Veiga, F.; Jarros, I.C.; Negri, M.; Svidzinski, T.I.E. Efficacy of Propolis Gel on Mature Biofilm Formed by Neocosmospora keratoplastica Isolated from Onychomycosis. J. Fungi 2022, 8, 1216. [Google Scholar] [CrossRef] [PubMed]
- Wang, T.; Pan, M.; Xiao, N.; Wu, J.; Wang, Q.; Cheng, T.; Yan, G.; Wu, D.; Li, N.; Shao, J. In vitro and in vivo analysis of monotherapy and dual therapy with ethyl caffeate and fluconazole on virulence factors of Candida albicans and systemic candidiasis. J. Glob. Antimicrob. Resist. 2021, 27, 253–266. [Google Scholar] [CrossRef] [PubMed]
- Ivanov, M.; Kostić, M.; Stojković, D.; Soković, M. Rosmarinic acid–modes of antimicrobial and antibiofilm activities of a common plant polyphenol. S. Afr. J. Bot. 2022, 146, 521–527. [Google Scholar] [CrossRef]
- Alexpandi, R.; Gopi, C.V.; Durgadevi, R.; Kim, H.J.; Pandian, S.K.; Ravi, A.V. Metal sensing-carbon dots loaded TiO2-nanocomposite for photocatalytic bacterial deactivation and application in aquaculture. Sci. Rep. 2020, 10, 12883. [Google Scholar] [CrossRef] [PubMed]
- Subramenium, G.A.; Swetha, T.K.; Iyer, P.M.; Balamurugan, K.; Pandian, S.K. 5-hydroxymethyl-2-furaldehyde from marine bacterium Bacillus subtilis inhibits biofilm and virulence of Candida albicans. Microbiol. Res. 2018, 207, 19–32. [Google Scholar] [CrossRef] [PubMed]
- Silva, S.; Negri, M.; Henriques, M.; Oliveira, R.; Williams, D.W.; Azeredo, J. Adherence and biofilm formation of non-Candida albicans Candida species. Trends Microbiol. 2011, 19, 241–247. [Google Scholar] [CrossRef] [PubMed]
- Abirami, G.; Alexpandi, R.; Durgadevi, R.; Kannappan, A.; Veera Ravi, A. Inhibitory effect of AMS against Candida albicans pathogenicity and virulence factor production: An in vitro and in vivo approaches. Front. Microbiol. 2020, 11, 561298. [Google Scholar] [CrossRef] [PubMed]
- Sinha, A.K.; Farooqui, S.A.; Sharma, A.; Mishra, A.; Verma, V. Reactivity of allyl methyl sulphide, the in-vitro metabolite of garlic, with some amino acids and with phospholipid involved in viral infections. J. Biomol. Struct. Dyn. 2022, 40, 565–571. [Google Scholar] [CrossRef] [PubMed]
- Sujithra, K.; Srinivasan, S.; Indumathi, D.; Vinothkumar, V. Allyl methyl sulfide, an organosulfur compound alleviates hyperglycemia mediated hepatic oxidative stress and inflammation in streptozotocin-induced experimental rats. Biomed. Pharmacother. 2018, 107, 292–302. [Google Scholar] [CrossRef] [PubMed]
- Cotter, G.; Kavanagh, K. Adherence mechanisms of Candida albicans. Br. J. Biomed. Sci. 2000, 57, 241. [Google Scholar] [PubMed]
- Azadmanesh, J.; Gowen, A.M.; Creger, P.E.; Schafer, N.D.; Blankenship, J.R. Filamentation involves two overlapping, but distinct, programs of filamentation in the pathogenic fungus Candida albicans. G3 Genes Genomes Genet. 2017, 7, 3797–3808. [Google Scholar] [CrossRef] [PubMed]

| Strains | Allyl Methyl Sulfide MIC90/MFC (µg/mL) | Fluconazole MIC90/MFC (µg/mL) |
|---|---|---|
| C. albicans ATCC 5314 | 200/400 | 8/16 |
| C. albicans ATCC 90028 | 250/500 | 10/18 |
Disclaimer/Publisher’s Note: The statements, opinions and data contained in all publications are solely those of the individual author(s) and contributor(s) and not of MDPI and/or the editor(s). MDPI and/or the editor(s) disclaim responsibility for any injury to people or property resulting from any ideas, methods, instructions or products referred to in the content. |
© 2023 by the authors. Licensee MDPI, Basel, Switzerland. This article is an open access article distributed under the terms and conditions of the Creative Commons Attribution (CC BY) license (https://creativecommons.org/licenses/by/4.0/).
Share and Cite
Hasan, Z.; Islam, A.; Khan, L.A. Signature Garlic Phytochemical as a Potential Anti-Candidal Candidate Targeting Virulence Factors in Candida albicans . Med. Sci. Forum 2023, 21, 50. https://doi.org/10.3390/ECB2023-14080
Hasan Z, Islam A, Khan LA. Signature Garlic Phytochemical as a Potential Anti-Candidal Candidate Targeting Virulence Factors in Candida albicans . Medical Sciences Forum. 2023; 21(1):50. https://doi.org/10.3390/ECB2023-14080
Chicago/Turabian StyleHasan, Ziaul, Asimul Islam, and Luqman Ahmad Khan. 2023. "Signature Garlic Phytochemical as a Potential Anti-Candidal Candidate Targeting Virulence Factors in Candida albicans " Medical Sciences Forum 21, no. 1: 50. https://doi.org/10.3390/ECB2023-14080
APA StyleHasan, Z., Islam, A., & Khan, L. A. (2023). Signature Garlic Phytochemical as a Potential Anti-Candidal Candidate Targeting Virulence Factors in Candida albicans . Medical Sciences Forum, 21(1), 50. https://doi.org/10.3390/ECB2023-14080

